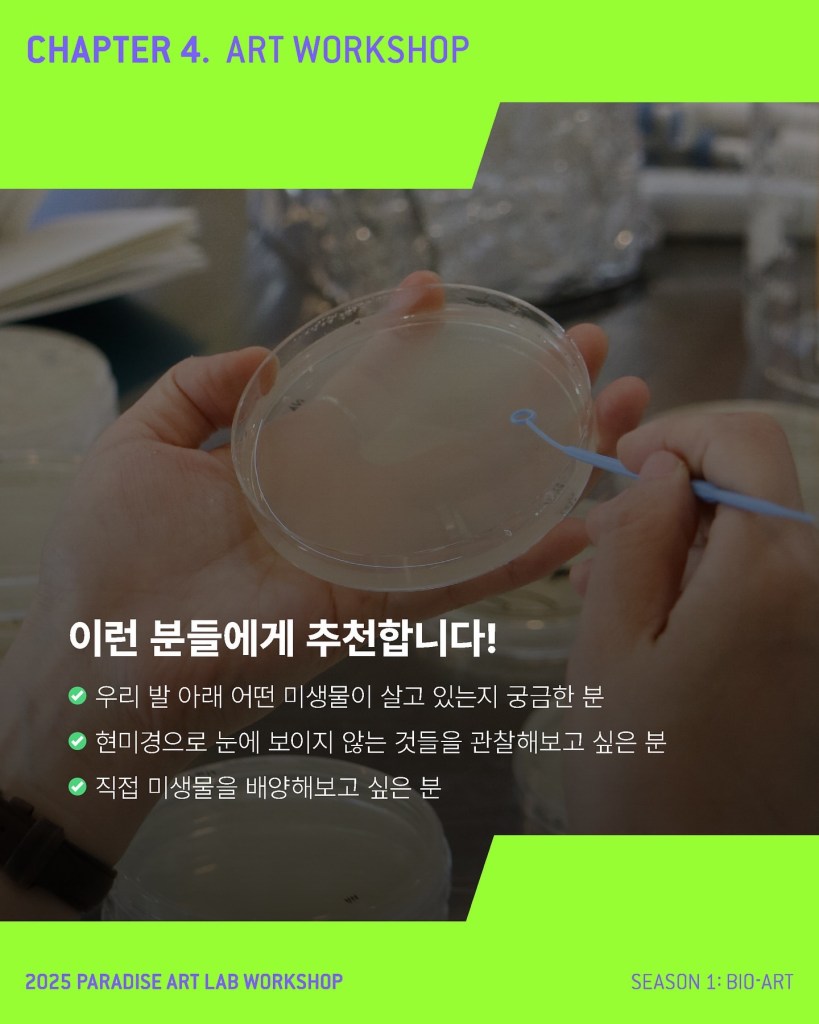

아트 & 바이오 랩 서울
(2024 – present)
바이오아트에 관심있는 예술가의 커뮤니티 공간으로 실험과 연구, 소통을 통해 작업세계를 확장시키고, 워크숍 형태로 대중을 만납니다.
📍 서울시 중구 퇴계로 299 1F 파라다이스 아트랩 워크숍
Workshop
우리 동네 미생물 아파트 만들기 (2025.11.5 – 11.19)
땅 속 보이지 않는 입주민, 미생물을 알아보고, 우리의 삶을 지탱하는 또 다른 생명 공동체를 만나봅니다. 위노그래스키 컬럼 만들기부터 현미경 관찰까지, 토양 미생물의 삶을 가까이 들여다보며 새로운 시선으로 우리 동네를 경험합니다.
– 1주차: 입주설명회
– 2주차: 입주준비
– 3주차: 이웃 만나기
열린 생물학 장비 기초 워크숍 (2025.8.4 – 8.14)
미생물 실험의 기초를 배우는 과정입니다. 실험 기기 사용법, 배지 제조, 미생물 배양 및 현미경 관찰을 단계적으로 실습합니다.
– 1회차: 미생물이란?
– 2회차: 배지 제작
– 3회차: 미생물 배양
– 4회차: 현미경 관찰
예술가를 위한 생물학 장비 기초 워크숍 (2025.6.9 – 6.19)
미생물 실험의 기초를 배우는 과정입니다. 실험 기기 사용법, 배지 제조, 미생물 배양 및 현미경 관찰을 단계적으로 실습합니다.
– 1회차: 미생물이란?
– 2회차: 배지 제작
– 3회차: 미생물 배양
– 4회차: 현미경 관찰
우리동네 미생물 지도 만들기 (2024.11.8 – 11.29)
우리의 감각 범위 밖에서 우리 사회를 묵묵히 지탱하고 있는 작고 보이지 않는 생명체. 그들에게 감사를 표하기 위해 그들의 존재를 드러내고 지도화합니다.
– 1회차: 미생물과 우리
– 2회차: 위노그라드스키 컬럼 만들기
– 3회차: 토양 미생물 배양하기
– 4회차: 배양한 미생물 마주하기